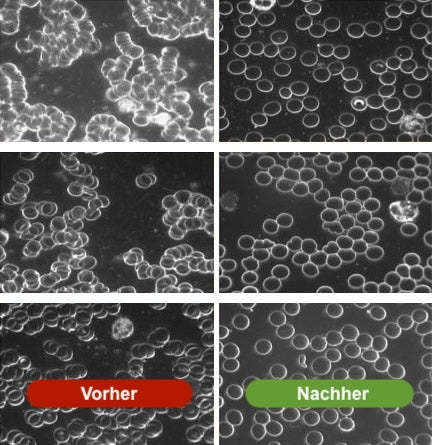

Elvari® Erdungsmatte
Elvari® Erdungsmatte
Unsere Erdungsmatte verbindet dich über den Erdungsleiter in der Steckdose mit den natürlichen Elektronen der Natur:
✓ Vitalität einfach von Zuhause steigern
✓ Natürliche Methode & einfache Anwendung
✓ Keine Nebenwirkungen
Verfügbarkeit für Abholungen konnte nicht geladen werden
⚠️ Hohe Nachfrage: Häufig ausverkauft
Wie funktioniert Grounding?
Wie funktioniert Grounding?
Wir Menschen haben immer eine gewisse elektrische Ladung. Diese Ladung verändert sich hin und wieder – du kennst das beispielsweise, wenn du einen Türgriff anfasst und es einen kurzen Blitz gibt.
Und wie du vielleicht noch aus dem Physik-Unterricht weißt: Die Erdoberfläche ist leicht negativ geladen.
Durch Reibung (beispielsweise zwischen unserer Haut und Polyester-Kleidung) kann unser Körper negative Ladung verlieren. Wir sind dann positiv geladen und in einem Ungleichgewicht.
👉 Dieses Ungleichgewicht wird durch direkten Kontakt mit der Erdkörper automatisch ausgeglichen. Positiv und negativ Ladungen wollen nämlich immer in Balance sein.
⚠️ Jetzt kommt das Problem: Wann hast du zuletzt auf dem Erdboden geschlafen? Wann bist du zuletzt barfuß auf der Erde gelaufen?
Unsere modernen Schuhe haben fast alle Gummi- oder Kunststoffsohlen und leiten keinen Strom. Sie verhindern damit diesen wertvollen natürlichen Ausgleich, den wir viele zehntausende Jahre hatten.
Und wer will heutzutage noch draußen auf dem hartem Erdboden schlafen, statt in gemütlichen Bett?
Die Lösung: Die Elvari® Erdungsmatte verbindet dich über den Erdungsleiter in deinem Zuhause direkt mit den heilenden Elektronen des Erdkörpers.
Zahlreiche Doppelblind-Studien bestätigen inzwischen die positive Wirkung des Erdens und zehntausende Grounding-Fans schwören darauf. Es lohnt sich also definitiv es einmal auszuprobieren.
👉 Durch unsere 30 Tage Garantie kann du die Elvari® Erdungsmatte einfach risikofrei bestellen und austesten. Probiere Grounding jetzt selbst aus!
Lieferumfang
Lieferumfang
- Elvari® Erdungsmatte (60x40cm)
- Erdungskabel (Bis zu 4 Meter)
- Erdungs-Adapter für EU-Steckdose
- Aufbewahrungsrolle
- Einfache Bedienungsanleitung
Nur bei Bundles:
ℹ️ Verschenkst du eine Erdungsmatte? Eine einmalige Prüfung mit dem Tester reicht – du kannst ihn danach verschenken!
🇨🇭 Für Schweizer Steckdosen wird ein CH-EU Adapter benötigt.
Noch Fragen zum Lieferumfang? Schreibe uns eine Mail an support@elvari.de oder auf WhatsApp.
Versand aus Deutschland
Versand aus Deutschland
📦 Lieferung innerhalb von 2-4 Tagen.
Wir versenden mit DHL GoGreen. Du erhältst nach deiner Bestellung eine Trackingnummer, mit der du deine Sendung verfolgen kannst.
🇨🇭Versand in die Schweiz:
Dank unseres Partners "MeinEinkauf" ist der Versand in die Schweiz einfach & kostenfrei. Wir kümmern uns um den Versand, Mehrwertssteuer und die gesamte Zollabwicklung.
90 Tage Grounding Garantie
90 Tage Grounding Garantie
Wir sind von der Qualität unserer Erdungsartikel so überzeugt, dass Du sie 90 Tage lang risikofrei testen kannst.
Solltest Du die Artikel zurückgeben wollen, erhältst Du von uns einen kostenfreien DHL-Rücksendeschein.
Nach Eingang der Ware in unserem deutschen Lager erstatten wir Dir den vollen Kaufpreis – abzüglich eines einmaligen Nachhaltigkeitsbeitrags von 10%.
*Ausnahmen für Schweiz & EU-Ausland siehe Rückerstattungsrichtlinien.










4800+ glückliche Kunden & Heilpraktiker ❤️

⌛ limitierte anzahl
Elvari® Erdungsbundle
Sichere dir die Elvari® Erdungsmatte, den Erdungsbezug und unseren Erdungstester im reduzierten Bundle:
- 46% Preisvorteil im Bundle
- 90 Tage Risikofrei Testen
wie die Erdungsmatte funktioniert
Die Vitalkräfte der Erde
Wir sind heutzutage konstant von elektrischen Geräten umgeben. Wir leben getrennt von der Natur und fühlen uns müde, gereizt, oder einfach nur gestresst. Wir stehen dauerhaft "unter Strom" und leiden an hohem oxidativem Stress...
Neue Forschung zeigt, dass wir uns durch "Grounding" wieder mit den vitalisierenden Elektronen der Natur verbinden können.
Ein einfacher Multimeter-Test des Elvari® Erdungsbezug zeigt das erstaunliche Ergebnis des Erdens.
Mögliche Wirkungen der Erdungsmatte
✅Es gibt inzwischen 30+ internationale Doppelblindstudien zur Wirkung von Grounding.
Die möglichen Wirkungen wie z.B. besserer Schlaf, geringeren Entzündungswerten und höherer Vitalität wurden von hunderten Berichten aus der Elvari Community im Einzelfall bestätigt.
Trotzdem ist Grounding aktuell (noch?) nicht schulwissenschaftlich anerkannt. Wir müssen aufgrund gesetzlicher Bestimmungen darauf hinweisen, dass der Einsatz keine Therapie beinhaltet und deshalb nicht die Konsultation eines Arztes ersetzt.
Wissenschaft
Zahlreiche Doppelblind-Studien bestätigen die positive Wirkung von Erdungsmatten
Grounding ist bekannt Journalen wie HealthLine, Sportärztezeitung, CBS, NBC und vielen weiteren.
- 10+ Doppelblind-Studien
- Forschung seit über 25 Jahren
- Keinerlei bekannte Nebenwirkungen
90 Tage Grounding-Garantie für die Elvari® Erdungsmatte
Wir sind von der Qualität unserer Erdungsmatte so überzeugt, dass Du sie 90 Tage lang risikofrei testen kannst.
Solltest Du deine Erdungsmatte zurückgeben wollen, erhältst Du von uns einen kostenfreien DHL-Rücksendeschein.
Nach Eingang der Ware in unserem deutschen Lager erstatten wir Dir den vollen Kaufpreis abzüglich eines Nachhaltigkeitsbeitrags von 10%.
Wie die Erdungsmatte funktioniert:
Beliebteste Erdungsartikel
Häufige Fragen zur Erdungsmatte
Reinigungsempfehlungen
Halte die Matte fern von direktem Sonnenlicht, um die Lebensdauer des PU-Leders zu verlängern.
Um die Matte zu reinigen, wische die Oberfläche mit milder Seife, Reinigungsmittel oder Reinigungstüchern ab. Anschließend mit Wasser abspülen und mit einem Tuch oder Küchenpapier trocknen.
Material
Oberseite: Leitfähiges Gemisch aus Carbon & PU
Unterseite: Kautschuk
Was ist Grounding?
Was ist der Unterschied zwischen Grounding und Earthing?
Wie funktioniert die Technologie hinter Erdungsartikeln?
Wie wirkt sich Earthing auf Hunde, Katzen und andere Haustiere aus?
Funktioniert die Matte auch, wenn ich in einer Wohnung lebe?
Senden Erdungsartikel EMF- oder Magnetfelder aus?
-
Noch Fragen? Unser Kundensupport ist für dich da! 😊
Schreibe uns eine Mail an support@elvari.de oder auf WhatsApp. Wir antworten werktags typischerweise innerhalb von 24 Stunden.
-
Verbinde dich mit der Erde – mit einer Elvari Erdungsmatte
Unsere Elvari Erdungsmatte im Format 60x40 cm bringt dir das vitalisierende Gefühl natürlicher Erdung direkt nach Hause!
Ob am Schreibtisch, auf dem Sofa oder im Bett – mit der Erdungsmatte holst du dir den direkten Kontakt zur Erde im Alltag zurück. Ganz bequem und ohne Aufwand.Warum eine Erdungsmatte verwenden?
Immer mehr Menschen entdecken die Vorteile von Earthing (Grounding) für sich – also dem direkten Kontakt mit der Erdoberfläche. Dieser natürliche Prozess ist leider in unserer modernen Welt mehr und mehr in den Hintergrund gerückt, da wir immer weniger Zeit in der Natur verbringen.
Studien und Erfahrungsberichte zeigen, dass "sich erden" eine positive Wirkung auf unseren Schlaf, unser Stresslevel, Entzündungen im Körper und auf unser allgemeines Wohlbefinden haben kann.Der Erdungsmatten-Effekt: wie barfuß in der Natur
Am natürlichsten funktioniert Grounding über den direkten Kontakt zum Erdboden – barfußlaufen in Wald und Wiese oder am Strand. Da viele Menschen aber in urbaner Umgebung in isolierten Wohnungen leben, ist der Gang in die grüne Natur leider häufig erschwert oder nur selten möglich.
Genau hier kommen unsere Erdungsmatten ins Spiel: Sie sind so entwickelt, dass sie die positive Wirkung des Groundings in der Natur imitieren. Die vitalisierenden Effekte vom Earthing kannst du so ganz unkompliziert zu Hause genießen! -
Wie verwendet man eine Erdungsmatte?
Die Anwendung unserer Erdungsmatte ist denkbar einfach. Du platzierst die Matte entweder auf dem Boden, wenn du dich über die Füße erden möchtest, oder auf dem Schreibtisch, wenn du dich über Hände und Unterarme erden möchtest.
Du kannst die Erdungsmatte auch im Bett verwenden. Fürs Bett bieten wir auch spezielle Erdungsbezüge an. Sofern du dich mit den Füßen erdest, ist es wichtig, dass du barfuß bist, oder Socken aus natürlichen (leitfähigen) Materialien wie reiner Baumwolle trägst.Anleitung: So nimmst du deine Erdungsmatte in Betrieb
Du verbindest die Erdungsmatte mit dem beiliegenden Erdungskabel, das du an den Erdungs-Adapter anschließt, den du vorher in eine Steckdose steckst. Keine Sorge: Es fließt kein Strom.Jetzt ist deine Erdungsmatte auch schon einsatzbereit.
Ob du einen direkten Effekt bei der Anwendung spürst, ist von Mensch zu Mensch unterschiedlich. Manche spüren ein angenehmes Kribbeln; bei anderen zeigen sich die Effekte erst langfristig – beispielsweise in Form von mehr Gelassenheit oder besserem Schlaf.Probiere es selbst aus und beobachte, wie du das Grounding mittels Erdungsmatte spürst!